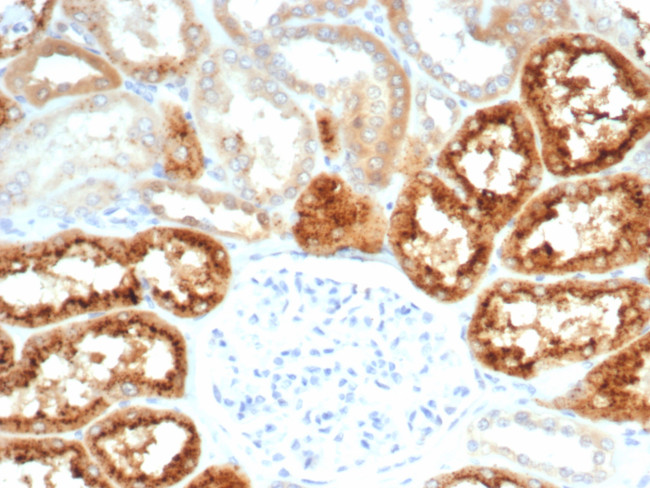
RBP4/Retinol Binding Protein 4 Antibody in Immunohistochemistry (Paraffin) (IHC (P))

Search
NeoBiotechnologies
RBP4/Retinol Binding Protein 4 Recombinant Rabbit Monoclonal Antibody (RBP4/7045R)
{{$productOrderCtrl.translations['antibody.pdp.commerceCard.promotion.promotions']}}
{{$productOrderCtrl.translations['antibody.pdp.commerceCard.promotion.viewpromo']}}
{{$productOrderCtrl.translations['antibody.pdp.commerceCard.promotion.promocode']}}: {{promo.promoCode}} {{promo.promoTitle}} {{promo.promoDescription}}. {{$productOrderCtrl.translations['antibody.pdp.commerceCard.promotion.learnmore']}}
产品信息
5950-RBM21-P1ABX
种属反应
宿主/亚型
Expression System
分类
类型
克隆号
抗原
偶联物
形式
浓度
规格
纯化类型
保存液
内含物
保存条件
运输条件
靶标信息
This protein belongs to the lipocalin family and is the specific carrier for retinol in the blood. It delivers retinol from the liver stores to the peripheral tissues. In plasma, the RBP-retinol complex interacts with transthyretin which prevents its loss by filtration through the kidney glomeruli. A deficiency of vitamin A blocks secretion of the binding protein post translationally and results in defective delivery and supply to the epidermal cells.
仅用于科研。不用于诊断过程。未经明确授权不得转售。
篇参考文献 (0)
生物信息学
蛋白别名: Plasma retinol binding protein 4 (PRBP); Plasma retinol-binding protein; PRBP; RBP; retinol; retinol binding; Retinol binding protein 4 interstitial; retinol binding protein 4, plasma; Retinol-binding protein 4; retinol-binding protein 4, interstitial; unnamed protein product
基因别名: MCOPCB10; PRO2222; RBP4; RDCCAS
UniProt ID: (Human) P02753
Entrez Gene ID: (Human) 5950